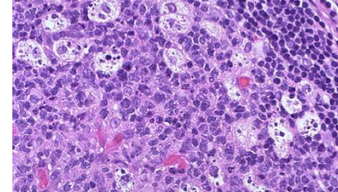
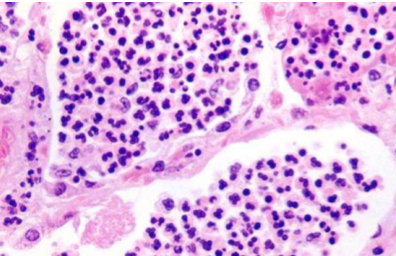
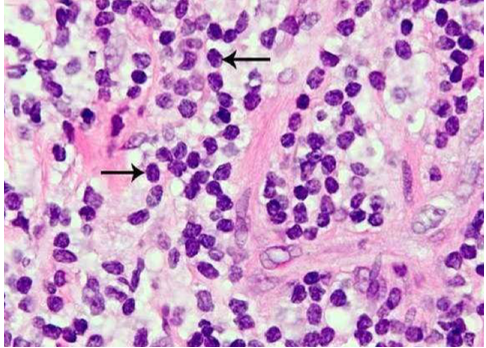

first questions to ask when given a tissue slide
we are looking at a …….. of a ….. structure in ….
We are looking at a cross section of 3D structure in 2D

the small bowel mucosa- cross section

Higher magnification versus lower magnification

what is this?
e.g. the more magnified version looks malignant, however when we take a step back it is clear that these are just the germinal centres of lymphoid tissue

what tissue is this

lung tissue
abnormal lung tissue can be due to
inflammation e.g. due to smoking
Neoplastic tissue

inflammation in the lungs e.g. due to smoking
normal architecture of the lung tissue not maintained–> alveoli form large air spaces and form bullae

if bullae burst
pneuothorax/ hard to breathe
neoplastic tissue benign vs malignant
benign tumours

malignant tumour

summary of interpreting histology speciment
eosin
acid- negatively charged attracted to positive molecules such as proteins in the cytoplasm
PINK

Haematoxylin
PURPLE
difference bertween hisotlogy versus cytology: what is cytology
histology
looking at cells in natural architecture
e.g. smear test
normal tissue from liver

normal tissue from skeletal muscle
commpon pathology: apoptotic body’s e.g. in the liver

Common pathology: Liquefactive necrosis of glomerulus

common pathology: acute inflammation
neutrophil polymorphs
common pathology: chronic inflammation
lymphocytes